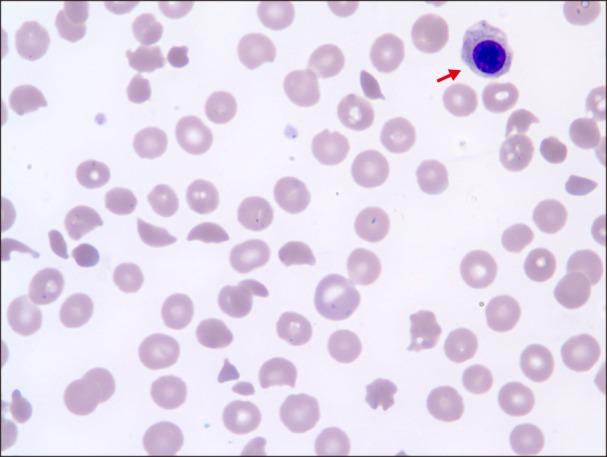
https://cdn.ncbi.nlm.nih.gov/pmc/blobs/8b42/6021567/c68df1565586/br-53-167-g001.jpg

Microangiopathic hemolytic anemia as initial presentation of recurrent colon cancer.
作者信息
Park Joowon
机构信息
Department of Laboratory Medicine, Dankook University Hospital, Cheonan, Korea.
出版信息
Blood Res. 2018 Jun;53(2):167-169. doi: 10.5045/br.2018.53.2.167. Epub 2018 Jun 25.
Abstract
摘要